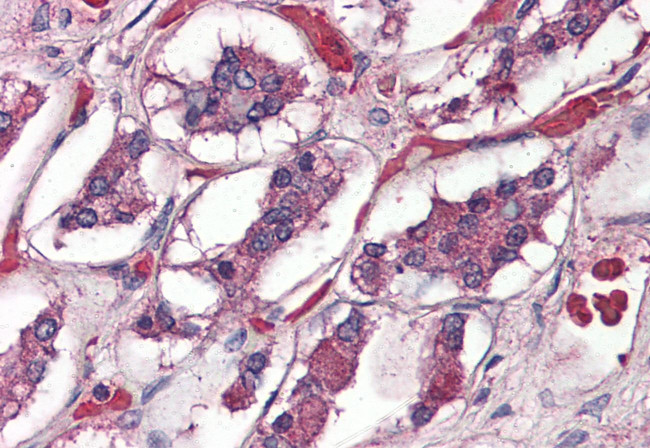
PACAP Receptor Antibody in Immunohistochemistry (Paraffin) (IHC (P))

Search
Invitrogen
PACAP Receptor Polyclonal Antibody
{{$productOrderCtrl.translations['antibody.pdp.commerceCard.promotion.promotions']}}
{{$productOrderCtrl.translations['antibody.pdp.commerceCard.promotion.viewpromo']}}
{{$productOrderCtrl.translations['antibody.pdp.commerceCard.promotion.promocode']}}: {{promo.promoCode}} {{promo.promoTitle}} {{promo.promoDescription}}. {{$productOrderCtrl.translations['antibody.pdp.commerceCard.promotion.learnmore']}}



Please note: We are reviewing Western blot images included in the antibody testing data in our catalog, including those provided by third parties. Unless expressly labeled or annotated as “raw-unedited”, Western blot images included in the antibody testing data in our catalog may have been edited, optimized or otherwise adjusted for presentation.
产品信息
PA5-33318
种属反应
宿主/亚型
分类
类型
抗原
偶联物
形式
浓度
规格
纯化类型
保存液
内含物
保存条件
运输条件
RRID
产品详细信息
Percent identity with other species by BLAST analysis: Human, Gorilla, Gibbon, Marmoset, Bovine (100%); Dog, Pig (94%); Mouse, Rat, Elephant, Panda (89%).
Antigen retrieval requires Proteinase K treatment.
靶标信息
This gene encodes type I adenylate cyclase activating polypeptide receptor, which is a membrane-associated protein and shares significant homology with members of the glucagon/secretin receptor family. This receptor mediates diverse biological actions of adenylate cyclase activating polypeptide 1 and is positively coupled to adenylate cyclase. Alternative splicing of two exons of this gene generates four major splice variants, but their full-length nature has not been determined. PACAP receptor type 1 expression has been documented in adipose, adrenal, bone, brain, colon, ganglion, heart, lung, ovary, pancreas, placenta, spleen, and uterus. ESTs have been isolated from brain and nerve libraries.
仅用于科研。不用于诊断过程。未经明确授权不得转售。
篇参考文献 (0)
生物信息学
蛋白别名: ADCYAP1 R1; ADCYAP1R 1; adenylate cyclase activating polypeptide 1 (pituitary) receptor type I; PAC 1; PAC1 receptor; Pac1 receptors; PACAP R 1; PACAP Receptor; PACAP type I receptor; PACAP-R-1; PACAP-R1; PACAP/VIP receptors; PACAP1 R; PACAP1 receptor; Pituitary adenylate cyclase-activating polypeptide type I receptor; pvr1
基因别名: ADCYAP1R1; PACAPR
UniProt ID: (Bovine) Q29627
Entrez Gene ID: (Bovine) 319095